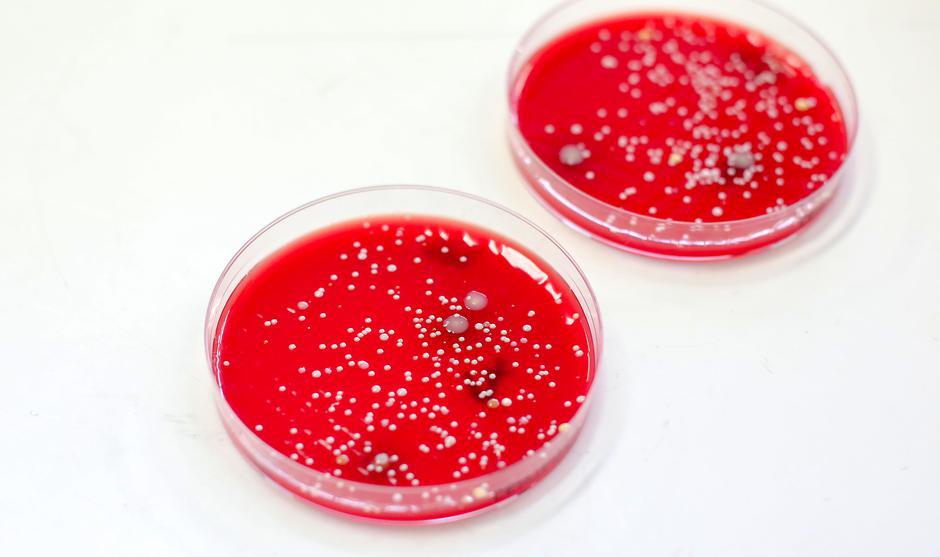
Bris mikroorganizmi | Avtor: Matija Habljak / PIXSELL

Doma sem najavila, da bom vzela bakteriološke brise v našem domu, nad čimer soprog ni bil najbolj navdušen. Nisi normalna, je bil njegov odziv, saj ga je bilo strah, kaj vse lahko najdemo. Imava namreč tri otroke, stare tri, sedem in 13 let. Najmlajši se slini in liže vse kar mu pride na pot, brez plenic je pol leta, a mu še vedno kdaj pobegne, polula se, kjer pač je – na tla, v kad, ob WC.
Drugi otrok ve, česa ne sme, ampak naravnost obožuje narediti nered. Tu je še najstarejša, najstnica, ki je po „poklicu“ bakteriofob. Naj povem še to, da je naš dom občasno videti, kot da smo padli iz serije Glavca (Malcom in the Middle), tako da se ne ve, kdo pri nas doma pije in kdo plača. So pa tudi dnevi, ko je vse na svojem mestu, ko smo vsi počesani in dišeči, stanovanje pa je videti kot iz pohištvenega kataloga. Lahko rečem, da smo ena povprečna družina v povprečnem domu.
Najprej je bila na vrsti kuhinjska pipa
Tudi upoštevajoč to, sem se vseeno odločila, da projekt speljem. Na predlog dr. Andrije Štampara iz zavoda za javno zdravstvo sem bris najprej vzela s perlatorja na kuhinjski pipi, ker je to potencialno skrito mesto za razvoj bakterij. Ponosna sem na svojo kuhinjo, ker v njej relativno dobro vzdržujem red, pipa pa je novejša in brez vodnega kamna, a imeli so prav.

„Pomislite, da vodo, ki teče skozi tak perlator, dodajate hrani, ki ne zahteva zavrete vode. S tem MO vnesete tudi v hrano, bakterije pa potrebujejo le malo časa, da se razmnožijo. V dobrih pogojih v 20 minutah iz vsake bakterije nastane nova, v 40 minutah iz teh dveh nastaneta še dve novi in tako naprej,“ opozarja zdravnica.
Jabolko še bolj umazano od perlatorja
Torej bi bilo dobro preveriti, kakšna voda teče iz takšne pipe. Na vprašanje, ali to pomeni, da bo jabolko bolj onesnaženo po pranju s to vodo, sogovornica vendarle odgovarja pomirjujoče: „Mislim da ne. Jabolka kupujemo v trgovinah in na tržnicah, kjer gredo čez veliko rok. Verjamem, da bi bilo zato na neopranem jabolku precej več MO, kot na pipi.“
Pomivalni stroj najčistejše mesto v stanovanju
Kljub temu sem bila vznemirjena, saj so sledili brisi z mest, kjer sem pričakovala še slabše rezultate. Najprej s pomivalnega stroja, ki je eden od mojih najboljših pomočnikov. Uporabljamo ga ves čas, čez vikend tudi po trikrat, a je bris z mesta, kjer izteka čista voda za izpiranje posode, ki sem ga vzela, potem, ko se je posoda oprala na 75 stopinj Celzija, pokazal, da je ta absolutno čist, ker laboratorijski testi niso potrdili niti ene same bakterije. Če bi bili MO prisotni, bi to pomenilo, da so tudi na vseh krožnikih, kozarcih, jedilnemu priboru ...

„Pomivalni stroj se kontaminira z MO, če vanj zlagamo posodo, s katere nismo očistili kosov oziroma ostankov hrane. Prašek preprosto ne more učinkovito opraviti svoje naloge, zato se v stroju s časom pojavijo MO,“ še opozori sogovornica.
Hladilnik, lahko bi bilo slabše
Naslednji je bil na vrsti hladilnik. Morala sem se prav zadržati, da ga pred odvzemom brisa nisem temeljito očistila, ker me je bilo strah, da bodo rezultati grozljivi. Moram biti poštena, hladilnika nisem temeljito očistila približno pol leta. Če se v njem kaj polije, ali se v njem znajde zelenjava z maminega vrta z zemljo vred, ali pa kakšna salama ali klobasica brez ovoja neposredno na polici, to očistim na hitro, z vlažno krpo, temeljitega čiščenja in dezinfekcije pa moj hladilnik že dolgo ni videl.
To ni mit, gobice za pranje posode so zelo umazane
Kmalu sem se prepričala, da umazanija na gobicah za pomivanje posode res ni mit. Zelo, zelo pogosto jih je treba menjati, ker kar ni na njej, v svetu mikrobov ne obstaja. To je dokazala tudi moja gobica, ki sem jo, preden sem vzela bris, uporabljala 14 dni.

Pričakovala sem, da rezultati z gobice ne bodo dobri, pa vendar sem s strahom vprašala: „Fekalne bakterije ste našli?“
„Da, ampak njihov izvor ni nujno straniščna školjka, lahko je sadje, zelenjava, vse, kar prihaja z zemlje, ker so v njej vse te bakterije,“ me je nekoliko pomirila.
Milo bolj umazano od WC-školjke
Naslednji bris sem vzela v vodi, ki se nabere na podstavku za milo. Z zanimanjem sem pričakovala rezultat, saj sem vedela, da MO še kako lahko rastejo tudi v milu. V vodi, ki je na podstavku stala 12 ur, od prejšnjega večera, je bilo 30 milijonov BK.

Kakšne so potem roke, ki si jih umijemo s takšnim milom? „Nismo preverjali brisa mila, temveč vode pod njim. Menim, da bosta milo in curek tekoče vode odstranila bakterije. Ni pa si pametno s takšnim milom umivati roke, na katerih so ranice in odrgnine, niti za obraz ga ne priporočam,“ je svetovala zdravnica.
Igračke v kopalnici so raj za bakterije
Kot mamo me je vedno grizlo, kakšne so plastične igračke, s katerimi se otroci igrajo med kopanjem. Vsake toliko pogledam v škatlo, v kateri so shranjene, in ugotovim, da se namakajo v ostankih vode, ki je odtekla iz njih, tudi vodni kamen najdem.

Dr. Ivančica Kovaček je še pojasnila, da je s hrano treba pojesti najmanj 100.000 BK, na primer salmonele, da bi se razvili simptomi zastrupitve, med katerimi so bruhanje, driska in povišana temperatura. Na naših igračkah jih je bilo 9000, precej manj od te meje, pa vendar ...
„Niti enega primera zastrupitve z enterobakterijami, ki so prisotne pri vas, še nismo zabeležili. Ampak pomislite; če vodo iz igračke popije zdrav otrok, ne bo nič, če pa jo popije otrok, v katerem se bolezen kuha, vi pa tega še ne veste, resnično ne vem, kako bi se odzvalo telo otroka v tem primeru.“
WC-deska dovolj čista za površino kuhinje
Vsaj nekaj je, na kar sem ponosna. Ob pomivalnem stroju je to še WC-deska. Bolj je čista od perlatorja na pipi in tudi od hladilnika, saj je bilo skupno število v mililitru le 30 kolonij. Tako je čista, da bi na njej lahko rezala salamo, saj zadosti bakteriološkim zahtevam za profesionalne kuhinje, sem pomislila.
A zdravnica je bila ostra: „Kljub temu nikar ne režite mesa na WC-deski, Čeprav so rezultati z nje verjetno boljši, kot bi bili z deske za rezanje mesa in zelenjave v kuhinji.“
Suhe površine niso problematične
Iskreno me je bilo strah, kaj bodo našli na lego kockah, ki so ves čas v uporabi. Vendar sem bila prijetno presenečena, ko sem izvedela, da je na njih le 120 BK. Še nekoliko boljši so bili rezultati z daljinskega upravljavca. Na njih je bilo manj MO kot na povprečnih rokah, umitih z milom.
„Zelo dobro. Gre za suhe površine, zato je razumljivo, da se na jih bakterije težje razmnožujejo.“
 In kaj smo našli na rokah triletnika?
In kaj smo našli na rokah triletnika?

Na koncu me je zanimalo še, kakšno je stanje, vsaj po moje, na največjem gojišču MO, mojem triletniku, ki ima ves čas viroze, trebušne in dihalne. Poleg tega ga je kot vsakega radovednega triletnika povsod dovolj, prav tako njegovih rok. Zanima ga vse, in ja, tudi WC bo poskušal s ščetko očistiti sam, tako kot odrasli, ki jih ves čas posnema. Prislonil bo tudi jezik na držalo v dvigalu, vzel dvolitrsko steklenico z mlekom iz hladilnika in ga poskušal natočit v najmanjši kozarec na svetu. Za njim ostajata kaos in moja bojazen, da povsod raznaša umazanijo. Zato sem bris vzela tudi z njegovih rok.
„Bris čistih rok običajno pokaže 200 bakterijskih kolonij. Malček je odličen, ker je njegov rezultat 180,“ je povedala zdravnica. Bila sem navdušena, saj sem bris vzela eno uro potem, ko sem mu umila roke, v tem času pa jih je med drugim uporabil tudi kot robček za nos.






www.Badoo.red - spletna stran za zmenke za odrasle, ki želijo najti partnerja za seks
www.Badoo.red - spletna stran za zmenke za odrasle, ki želijo najti partnerja za seks
www.Badoo.red - spletna stran za zmenke za odrasle, ki želijo najti partnerja za seks